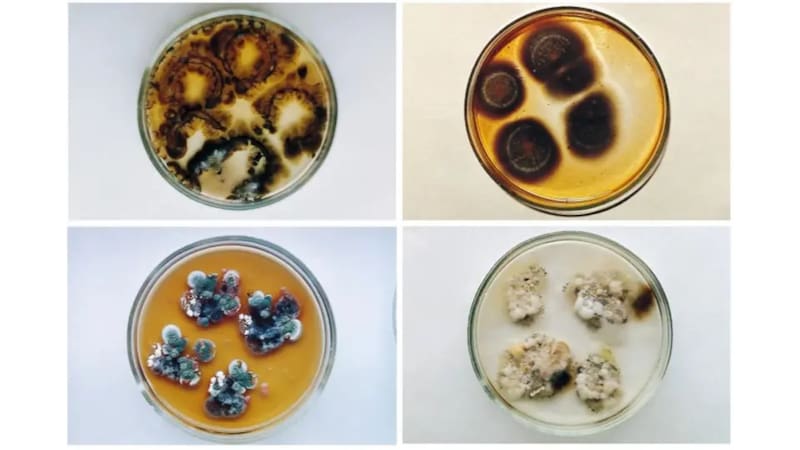
¿Vida en Chernóbil? Tras 39 años del desastre, la NASA halló el único ser vivo que sobrevivió y no le afectó la radiación. Foto: Elsevier/ Zhdanova et al. 2000

La zona de exclusión de Chernóbil sigue siendo tan radioactiva que puede destruir el ADN de cualquier ser vivo en segundos, más allá de que hayan pasado 39 años del accidente nuclear. Sin embargo, la ciencia ha revelado un superviviente inesperado: un hongo negro.
No solo resiste la radiación, sino que parece “alimentarse” de ella. La NASA, fascinada por este descubrimiento, lo estudia en el espacio y ahora lo ve como la clave para proteger a los astronautas en misiones a la Luna y Marte.
Así fue el desastre de Chernóbil hace 39 años
El 26 de abril de 1986, la explosión en el reactor número 4 de la central nuclear de Chernóbil liberó una nube radiactiva que contaminó Europa y obligó a evacuar a más de 300.000 personas. La zona de exclusión de 30 km alrededor del sitio se convirtió en un “cementerio radiactivo”, inhabitable para humanos.
No obstante, la naturaleza volvió a florecer dentro de este terreno imposible con avistaje de lobos, jabalíes y aves que regresaron. Los animales no son lo sorprendente, sino que existe un microorganismo que prospera donde todo lo demás perece: el hongo Cladosporium sphaerospermum, un moho negro que coloniza las ruinas del reactor.
Este hongo fue descubierto en 1997 por la microbióloga ucraniana Nelli Zhdanova, quien encontró 37 especies de hongos oscuros creciendo en techos, paredes y conductos metálicos altamente radiactivos. No se trataba de un error, dado que estos hongos exhiben radiotropismo, un comportamiento donde crecen hacia las fuentes de radiación, en lugar de huir de ellas, desafiando las leyes de la supervivencia.
¿Por qué estos hongos son inmunes a la radiación?
La clave está en la melanina, un pigmento oscuro que llena las paredes celulares del hongo, dándole su apariencia negra. En los humanos, la melanina en la piel oscura protege contra la radiación UV; en el hongo de Chernóbil, actúa como un escudo contra la radiación ionizante, miles de veces más destructiva. Esa capa absorbe la energía radiactiva y la disipa como calor, neutralizando iones reactivos que dañarían el ADN.
El descubrimiento tiene más sorpresas: en 2007, la radiofarmacóloga Ekaterina Dadachova descubrió que estos hongos melanizados crecen hasta un 10% más rápido en presencia de cesio-137, un isótopo radiactivo común en Chernóbil.
Dadachova propone la radiosíntesis, que es similar a la fotosíntesis, pero usando radiación ionizante en lugar de luz solar. “La energía de la radiación es un millón de veces mayor que la de la luz blanca. La melanina actúa como un transductor, convirtiéndola en energía utilizable”, explicó la experta a la BBC. Solo 9 de 47 especies de hongos melanizados muestran este efecto, lo que hace al Cladosporium sphaerospermum único.
¿Cómo podría ayudar a la NASA este hongo?
Intrigados por su potencial, la NASA envió muestras de este hongo a la Estación Espacial Internacional (ISS) en 2018 y 2020. En un estudio de 2022 liderado por el bioquímico Nils Averesch de la Universidad de Florida, el hongo creció unas 1,21 veces más rápido bajo radiación cósmica galáctica y microgravedad durante 26 días, comparado con controles en Tierra. Incluso capas delgadas de biomasa bloquearon parte de la radiación, demostrando su eficiencia como escudo biológico.
La astrobióloga de la NASA Lynn J. Rothschild lo compara con “una tortuga que lleva su caparazón a todas partes”: en lugar de transportar materiales pesados como plomo o agua para protección, los astronautas podrían cultivar estos hongos en el sitio.













